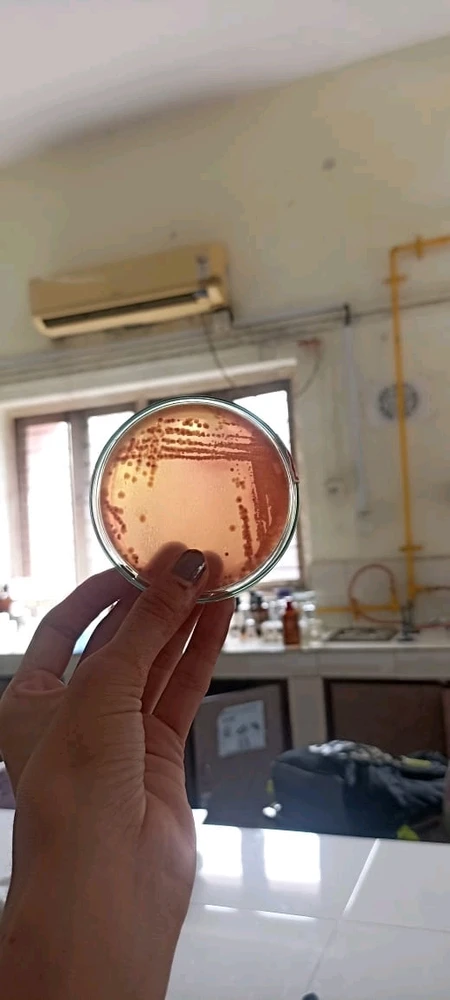
Image uploaded by Om Shah
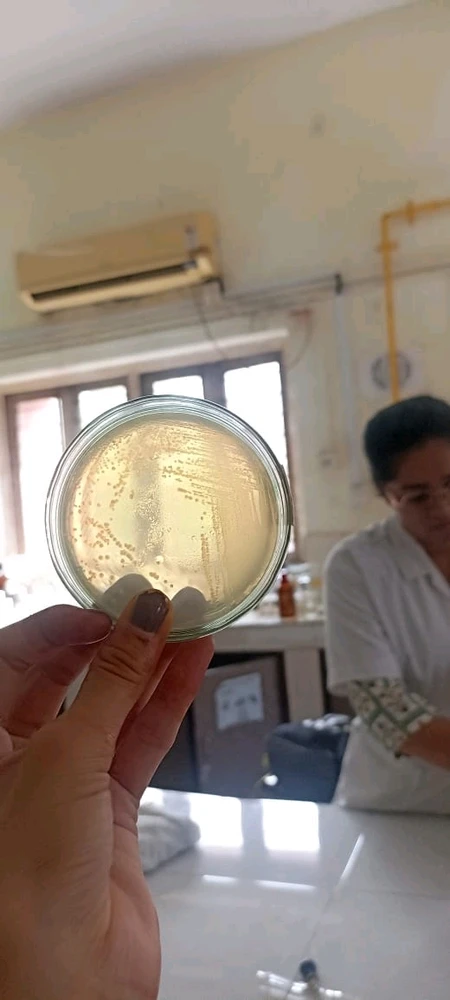
Image uploaded by Om Shah

Microorganisms Community
The microorganisms community, chat, and discussion.
6 souls
6 souls
No posts yet!
Meet New People
50,000,000+
DOWNLOADS
2.3M souls
10K souls
6 souls
11K souls
3.8K souls
2.2K souls
1.9K souls
980 souls
908 souls
843 souls
831 souls
666 souls
610 souls
473 souls
462 souls
454 souls
440 souls
437 souls
380 souls
377 souls
344 souls
318 souls
308 souls
279 souls
268 souls
225 souls
216 souls
199 souls
177 souls
162 souls
151 souls
123 souls
116 souls
105 souls
105 souls
102 souls
96 souls
82 souls
74 souls
68 souls
67 souls
61 souls
51 souls
51 souls
50 souls
49 souls
49 souls
46 souls
42 souls
40 souls
38 souls
36 souls
35 souls
30 souls
30 souls
28 souls
28 souls
27 souls
26 souls
25 souls
25 souls
25 souls
22 souls
21 souls
20 souls
20 souls
19 souls
19 souls
18 souls
18 souls
17 souls
16 souls
16 souls
16 souls
16 souls
15 souls
15 souls
14 souls
14 souls
14 souls
14 souls
13 souls
12 souls
12 souls
11 souls
11 souls
10 souls
9 souls
9 souls
9 souls
9 souls
8 souls
8 souls
8 souls
8 souls
8 souls
7 souls
7 souls
6 souls
6 souls
6 souls
5 souls
5 souls
5 souls
5 souls
5 souls
5 souls
5 souls
4 souls
4 souls
4 souls
4 souls
4 souls
3 souls
3 souls
3 souls
2 souls
2 souls
2 souls
2 souls
2 souls
2 souls
2 souls
2 souls
1 souls
1 souls
1 souls
1 souls
0 souls
The microorganisms community, chat, and discussion.
6 souls
6 souls
No posts yet!
Meet New People
50,000,000+
DOWNLOADS
Related Posts
1mo
ISTP
Pisces
In Hermann Hesse’s famous book Siddhartha, there is a character named Vasudeva. Vasudeva says to Siddhartha, the main character, “I have learned from the river; you too should learn from the river. The river teaches everything.” What does Vasudeva mean by learning from the river? Please... (edited) read more


20
6
4mo
INFJ
In our culture, there’s a deep-rooted belief that we are not born randomly — we come to this earth to fulfill a karmic cycle, often as a result of actions or desires from past lives. Life, as we know it, is not just a one-time occurrence but a long journey of transformation and purification. We... read more
4
1
7mo
ENTP
Taurus

2
3
11mo
ENTJ
Virgo
We either assume that bacteria and other microorganisms just aren't qualified observers when it comes to the observer effect, or we assume they've never been present for any experiments. Who's going to be the first person to test to see if, say, a cat can control superposition? (edited)

1
1
3y
ISTP
Libra
This is a relatively new concept that explores the link between the gut microbiome and mental health. While research in this area is still in its early stages, there is growing evidence to suggest that the gut microbiome may play a role in various mental health conditions, such as depression and... (edited) read more

72
23
1y
INFP
Leo
Honey's longevity lies in its unique composition: it's highly acidic and low in moisture, making it an inhospitable environment for bacteria and microorganisms. Additionally, when bees make honey, they add an enzyme that produces hydrogen peroxide, a compound that helps to prevent the growth of... read more
8
7